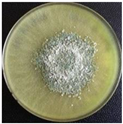
Fermentation 09 00385 i005
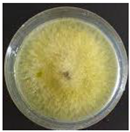
Fermentation 09 00385 i010

Abstract
Enzymes are highly effective biocatalysts used in various industrial processes, playing a key role in winemaking and in other fermented beverages. Many of the enzymes used in fermentation processes have their origin in fruits, in the indigenous microbiota of the fruit, and in the microorganisms present during beverage processing. Besides naturally occurring enzymes, commercial preparations that usually blend different activities are used (glucosidases, glucanases, pectinases, and proteases, among others). Over the years, remarkable progress has been made in enhancing enzyme performance under operating conditions. The winemaking industry has observed a significant improvement in production levels, stimulating the introduction of technological innovations that aim to enhance efficiency and wine quality. Enzymes have traditionally been used in the beverage industry; however, others have been introduced more recently, with numerous studies aimed at optimizing their performance under processing conditions, including the use of immobilized enzymes. Therefore, one major goal of the current review is to give a detailed overview of the endogenous enzyme potential of wine microorganisms, as well as of enzymes obtained from grapes or even commercial preparations, studied and already in use in the beverage industry, and to present the future trends in enzyme production and application.
1. Introduction
Enzymes are biocatalysts that accelerate biochemical reactions in living organisms. They can also be extracted from cells and used to catalyse several important industrial processes [1]. Enzymes were discovered in the second half of the nineteenth century, and in 1878, the German physiologist Wilhelm Kühne was the first scientist to use the word ‘enzyme’ when explaining the process of sugars fermentation by yeast. The word derives from the Greek words en (meaning ‘within’) and zume (meaning ‘yeast’) [1].
Enzymes are, normally, globular proteins and consist of long linear chains of amino acids that fold to produce a three-dimensional structure. Enzymes are extremely efficient and highly specific biocatalysts playing a pivotal role in the beverage production processes. For example, in wine production, many of the biotransformations occurred by employing the enzymes produced in the indigenous microflora on the grape and in the microorganisms present in the winemaking [2,3].
With the advance of biotechnology and the understanding of the function of enzymes, commercial enzyme preparations are nowadays used at different stages of the process in the beverage industry (alcoholic and non-alcoholic beverages) to obtain better quality products [3,4,5]. For example, they are used to accelerate solid settling and clarification and improve colour extraction, and they can also be used for achieving better extraction performances by increasing juice yield and increasing processing efficiency such as pressing [6]. Commercial enzyme preparations act like the natural enzymes from grapes and yeast, but with improved selectivity, activity, and stability under operational conditions [3]. In the beverage industry, the application of enzymes is a gainful option, which improves yields and, at the same time, reduces carbon footprint, energy consumption, and environmental pollution [7,8,9].
Enzymes can be used as food additives and/or processing aids. Most of them are used as processing aids, whereas others, such as lysozyme and invertase, are used as additives [10]. Among all groups of food and beverage enzymes, amylases, pectinases, and cellulases are extensively used in the beverage industry [8].
This review aims to give a detailed overview of the sources of the enzymes from grapes, wine microorganisms, or even commercial preparations, that are used in the production of alcoholic and non-alcoholic beverages. Additionally, it aims to highlight future trends in enzyme production and application.
2. Enzymes Produced by Fungi (Moulds and Yeasts) in the Beverage Industry
According to Markets and Markets [11], the food enzymes market is forecasted to grow by $914.04 mn during 2022–2027, accelerating at a CAGR of 6.28% during the forecast period. The advancements in R&D, environmental concerns, and urbanisation, among others, led to the growth of this market. In addition, the progressions in technology (enzyme engineering, introduction of genetically engineered enzymes) have increased the growth of the food industry. Enzymes are used in various food applications, including baking, brewing, dairy, oil/fats, beverage, juice, and wine [12], and most of the commercial enzymes used in food and beverages are mass-produced using fungal hosts—both yeasts (unicellular) and filamentous fungi (multicellular), Table 1.

Table 1.
List of approved enzyme activity for use as processing aids in food in Europe. For each product, the fungal or bacterial origin of the host organism is shown (colonies formed on Petri dishes in Potato-Dextrose Agar-PDA). Adapted from [13].
The yeast Saccharomyces cerevisiae has been widely used for food and alcoholic drinks due to its ability to ferment sugars into ethanol and carbon dioxide. Filamentous fungi or moulds have also been used for food and beverage production. As an example, miso is a traditional Japanese seasoning processed using Aspergillus oryzae and A. sake for the fermentation of soybean, barley, or rice. However, fungi can also be an important component of the final food product (Penicillium roqueforti strains used in blue cheese) [13]. In 1894, the manufacturing of an enzyme complex from A. oryzae was developed to produce different enzyme products in submerged fermentation [13]. However, the development of commercial sources of glucoamylase was the basis for the enzyme revolution in the starch industry [14].
From Table 1, we can exemplify some fungal enzymes, such as: (i) Glucoamylases (EC 3.2.1.3) that are exo-acting enzymes that catalyse the hydrolysis of polysaccharide starch from the non-reducing end, releasing β-glucose. These enzymes are produced by Aspergillus niger, A. awamori, and Rhizopus oryzae and are widely used for industrial applications [15]. They are found in a wide range of applications in the beverage industry, such as the production of sweet syrups (high-glucose and high-fructose), and play an important role in the production of sake, soya sauce, as well as light beer [16]. (ii) Acidic protease from Aspergillus usamii has been employed for the enhancement of functional properties of wheat gluten, allowing the release of peptides and amino acids for proper fermentation, not only for bread making but also for beer making, as they are efficient even at low pH by balancing the amino acid profile of beer [16,17]. (iii) Lipases, produced by A. niger or A. oryzae, are used in wine production to modify wine aroma [16]. (iv) Pectinolytic enzymes (polygalacturonase and pectase) are produced by Aspergillus spp. and are widely used for juice clarification, increasing juice yield prior to the grapes’ fermentation [18]. Invertase is produced from Saccharomyces spp. cells through the application of a proteolytic enzyme [18].
3. Enzymes Produced by Lactic Acid Bacteria in the Beverage Industry
Lactic acid bacteria (LAB) constitute one of the most important and relevant microbial groups in the food area due to their role in the production and quality of a diverse myriad of foods dispersed worldwide. This is the result of a complex metabolic activity. Thus, these bacteria are a huge source of enzymes, and their status as Generally Recognized as Safe (GRAS) microorganisms will help in this purpose. The only limitation that may compromise the industrial production of enzymes extracted from LAB is the slow growth of some strains, particularly ones isolated from wines—hence their direct use in wines to obtain the intended and desired biochemical transformations. Indeed, using whole cells, rather than purified enzymes, provides a series of advantages since whole cells are a natural environment for enzymes, preventing loss of activity in non-conventional media, and they can efficiently regenerate co-factors [19,20].
The main enzymes of wine LAB strains are the Malolactic enzymes, Glycosidases, Esterases, Lipases, Proteases, and Tannases.
Malolactic Enzyme-EC. 4.1.1.101– Malolactic Fermentation (MLF) is defined as the biotransformation of L-malic acid to L-lactic acid and carbon dioxide by the malolactic enzyme that exists in all LAB strains (formerly Lactobacillus, Pediococcus, Leuconostoc, and predominantly Oenococcus) isolated from grapes, must, and wine samples. This secondary fermentation, which usually occurs after alcoholic fermentation has been completed, is equally very important in red wines and specific wines and results in significant physicochemical and sensory modifications [21,22]. In addition to deacidification (the immediate effect of a decrease in acidity by the transformation of a dicarboxylic acid (L-malic acid), which is characterised by a harsh taste, into a monocarboxylic acid (L-lactic acid) with a milder taste) of the wine, with concomitant modification of its gustatory and olfactory perception, MLF contributes significantly to microbial stability (by the removal of L-malic acid, a potential carbon source for some spoilage microorganisms [23,24]) and often to the improvement of the sensory profile of wines. Modifications in wine aroma by LAB are due to L-lactic acid, less aggressive to the palate, but also due to a huge number of other compounds, such as diacetyl, acetoin, 2,3-butanediol, ethyl lactate, and diethyl succinate esters, and some higher alcohols and aromatic aglycones that become free by the action of LAB β-glucosidases [25,26,27,28].
Glycosidases-EC 3.2.1.21 β-D-Glucoside glucohydrolases; (Glycosidasic activity)—The varietal aroma of wines is given by volatile compounds that are mostly found in grapes in the form of non-volatile odourless molecules conjugated with monoglycosides (β-D-glucose) and diglycoside (β-D-glucose and a second sugar unit of α-L-arabinofuranose, α-L-rhamnopyranose, β-D-xylopyranose, or β-D-apiofuranose) [29]. Different classes of volatiles, including monoterpenes and C13-norisoprenoids, are the aglycon moiety that constitutes these glycoconjugate compounds. Although the acidic hydrolysis during wine ageing can transform them into free volatile aroma compounds, a slow process and faster enzymatic hydrolysis of these glycoconjugates are performed by wine microorganisms. Thus, the liberation of the odorous aglycon is achieved by the action of the β-D-glucosidase enzyme, being necessary for diglycosides prior to the activity of an appropriate exo-glycosidase [30]. According to Grimaldi et al. [31], O. oeni strains possess β-D-glucopyranosidase, α-D-glucopyranosidase, and β-D-xylopyranosidase activities but also minimal α-L-rhamnopyranosidase and α-L-arabinofuranosidase activities. Lactobacillus spp. and Pediococcus spp. also possess varying degrees of β-D-glucopyranosidase and α-D-glucopyranosidase activities, although approximately one order of magnitude less than those seen for O. oeni.
Although the β-glucosidase activity is strain dependent, it is present in all species capable to perform MLF. Numerous works have shown the ability of many Oenococcus oeni strains to hydrolyse grape glycoconjugate aroma precursors with differences in the extent and specificity of β-glucosidase activity [31,32,33,34]. The variability observed in different strains is a consequence of the influence of pH, sugar, and ethanol content of wine on β-glucosidase activity [32].
Lactiplantibacillus plantarum [35] (formerly Lactobacillus plantarum) strains isolated from South African wines [36] and Italian wines [37] showed β-glucosidase activity and the ability to release odorant aglycones from odourless glycosidic aroma precursors. Due to a more diverse enzyme profile observed in Lactiplantibacillus plantarum when compared with O. oeni strains, particularly with regards to the presence of the aroma-modifying enzymes β-glucosidase and phenolic acid decarboxylase (PAD), Krieger-Weber et al. [38] suggest and recommend the future use of this species in the modification of wine aroma profile and use as a commercial starter culture.
However, it is important to point out that, sometimes, glycosidase activity can also damage the final product quality by the increase in smoke taint-associated aromas [39,40] when some volatile phenols are the glycoconjugate compounds, or impacting wine colour when anthocyanin glucosides are involved [40].
Esterase-EC 3.1.1.6 acetyl ester hydrolases (Esterase activity)—Wine esters are secondary or tertiary aroma compounds that contribute significantly to wine aroma [40,41]. These compounds are produced by yeasts during alcoholic fermentation and by LAB during MLF [41] via ester hydrolysis through esterase activity and also by slow chemical esterification [41] between alcohol and acids during wine aging [42]. The main esters in wine include ethyl esters of organic acids (e.g., ethyl lactate), fatty acids (e.g., ethyl hexanoate, ethyl octanoate, ethyl decanoate), and acetates of higher alcohols (e.g., ethyl acetate, isoamyl acetate) [41]. There are many references to the role of LAB in the ester composition profile of wines after MLF produced worldwide [43,44,45,46]. Although all wine LAB species of Lactobacillus, Pediococcus, and Oenococcus possess esterase activity, strains of O. oeni have shown the highest activity [47]. The degree of LAB contribution to the ester profile of the wine is strain-specific [28,48] and is conditioned by factors such as pH, temperature, and ethanol concentration [47]. Sumby et al. [28] realized that O. oeni esterases can hydrolyse and also synthesise esters of short-chained fatty acids, the degree of each activity being conditioned by strain and by wine composition. Additionally, according to Lasik-Kurdy et al. [49] results, the MLF inoculation strategy can affect the quantity and quality of esters released by the bacteria, with the co-inoculation technique showing an increase in the release of ethyl esters (ethyl lactate, diethyl succinate, and ethyl acetate), that may enhance the wine with floral and fruity notes, depending on their concentration.
Lipase-EC 3.1.1.3 triacylglycerol acylhydrolases (Lipase activity)—By their action, wine lipids are cleaved, rendering different volatile compounds (esters, ketones, aldehydes) and fatty acids. While the former may have a positive effect on wine flavour, the odours of fatty acids are usually not desirable [50]. Lipase activities are present in all genera of wine LAB. In a survey performed by Matthews et al. [51] in LAB isolated from Australian wines, for enzymes of interest in oenology, lipase activity was restricted to three Lactobacillus isolates. From palm wine, Nkemnaso [52] recovered six LAB isolates—Lactiplantibacillus plantarum, Lactiplantibacillus pentosus, Levilactobacillus brevis, Limosilactobacillus fermentum [35], formerly Lactobacillus plantarum, Lactobacillus pentosus, Lactobacillus brevis, Lactobacillus fermentum-, Lactococcus spp., and Leuconostoc spp.) with lipase activity.
Proteases and peptidases (Proteolytic activity)—Although, having complex nutritional requirements, O. oeni and other wine LAB strains belonging to other species responsible for MLF cannot utilize inorganic nitrogen sources, contrary to the fermentation yeast Saccharomyces cerevisiae. Instead, sufficient amounts of organic nitrogen in the form of amino acids and peptides must be supplied or be present in musts or wines [38]. Thus, some works have characterised proteolytic enzymes in O. oeni strains [53,54,55,56] and in wine Lactobacillus strains [57] that may help to gain access to rare nitrogen sources during MLF [56]. According to the results obtained by Aredes Fernández et al. [5], the utilisation of Oenococcus oeni with proteolytic activity to carry out the MLF would contribute to enhancing the beneficial biological activities (antioxidant and antihypertensive activity) of the final product and provide an additional value to regional wines. Wine LAB proteolytic activities could be exploited in winemaking and have the potential to replace or reduce the use of fining agents such as bentonite for the removal of unwanted wine proteins [38].
Tannase-EC 3.1.1.20 (Tannase activity)—The activity of taninoacil hydrolase enzyme, commonly termed tannase, reduces wine astringency and turbidity and may increase the quality of wine and result in a better and pleasant sensory perception for consumers. This activity was observed in strains of Lactiplantibacillus plantarum [35] (formerly Lactobacillus plantarum) [5,58,59,60] and Limosilactobacillus frumenti [35] (formerly Lactobacillus frumenti) [59] Oenococcus oeni [50,61] and Pediococcus [51].
Other enzymes (Enzymatic activity)—Also very important is the ability of some LAB strains to produce enzymes that degrade biogenic amines (BAs) and mycotoxins. Aromatic amines such as tyramine, phenylethylamine, tryptamine, or serotonin are another class of compounds that can be oxidized by laccases [4,50]. Two laccases (multicopper oxidases) extracted from a wine strain Lactiplantibacillus plantarum J16 and a cereal strain Pediococcus acidilactici CECT 5930 were identified and characterized [62,63], revealing BA degradation. Additionally, Olmeda et al. [64] characterised Pediococcus laccases of P. acidilactici 5930 and Pediococcus pentosaceus 4816 strains. A Lactiplantibacillus plantarum strain (CAU 3823) was able to degrade biogenic amines in culture media conditions and Chinese rice wine at the end of post-fermentation [65]. The authors defend the approach of using strains such as this one as an efficient method to decrease the biogenic amine contents in traditional fermented food made by multiple microbes such as wine, rice wine, sausages, vinegar, cheese, and kimchi, among others.
Regarding detoxification activity, LAB are on the top of the list of microorganisms for the degradation of mycotoxins due to their GRAS status as mentioned before. For detoxification of mycotoxins in foods, LAB may use two mechanisms: (i) using the viable cell of the microorganisms and/or (ii) using the enzymes produced by certain LAB strains [66]. In a group of LAB isolated from Douro wines and identified as belonging to O. oeni, Lactobacillus plantarum, Pediococcus parvulus, Abrunhosa et al. [67] detected biodegradation of ochratoxin A (OTA) in a synthetic medium only in Pediococcus parvulus strains able to degrade OTA. Due to the OTA degradation ability of these strains, potential biotechnological applications to reduce health hazards associated with this mycotoxin may be exploited not only in the wine industry but also in other food industries (sausage, beer) and feedstuff for animals [68].
4. Enzymes from Grapes and Commercial Preparations Used in Wines Production
In wine production, enzymes are required for the biotransformation processes that convert grape juice into wine. These processes are performed by enzymes from microorganisms (yeasts, fungi, bacteria) and grapes but also by commercial enzymatic preparations added exogenously [3,69], Figure 1.

Figure 1.
Schematic representation of red wine’s conventional production process, showing the stages at which enzymes could be added. Adapted from Ray et al. [70].
Thus, enzymes can be used throughout the winemaking process. Their use improves the extraction of anthocyanins from the red berry skins, thereby increasing the colour intensity of the resulting wine, which is an important quality parameter in red wines. At this stage, commercial enzyme preparations are mainly characterised by the activities of pectolytic enzymes, namely polygalacturonase, pectin methylesterase, pectin lyase, cellulases, hemicellulases, and acid proteases [70,71], Figure 1.
Pectinases, xylanases, glucanases, and proteases are used to improve clarification and filtration. These enzymes can increase pressing efficiency and juice extraction [72], Figure 1. The rupture of grape-cell structures by these enzymes favours the extraction of substances contained in the pulp and in the skin, improving the extraction and clarification processes of the grape must, while also extracting substances that impact the aroma and colour of the final wine [4,72].
Once the alcoholic fermentation finishes, contact with lees takes place. Wine lees are defined as ‘the residue that forms at the bottom of the vessel containing wine after alcoholic fermentation during the storage or after authorised treatments, as well as the residue obtained following the filtration or centrifugation of this product in accordance with EEC regulation No. 337/79. Lees are mainly composed of dead yeasts and bacteria, tartaric acid, and inorganic matter [73]. Yeast autolysis occurring after cell death involves the hydrolysis of biopolymers under the action of hydrolytic enzymes such as β-glucanases and proteases, releasing peptides, amino acids, fatty acids, and nucleotides from the yeast cytoplasm to the wine. Glucans and mannoproteins from the yeast’s cell wall are also released and influence significantly the stability and the final sensory properties of the wines. Aiming at reducing the wine’s contact with lees and preventing the risks of oxidation and microbial contamination, enzymatic preparations rich in β-glucanases can be used. Exogenous glucanases can catalyse the hydrolysis of β-(1-3) and β-(1-6)-glycosidic bonds of the cell wall β-glucan chains, progressively degrading the cell wall and accelerating the yeast lysis [73,74].
Other enzymes may be used with the aim of improving wine varietal aroma by releasing glycosidic aroma precursors that are stable during winemaking operations since the glycosidases activity of S. cerevisiae is somewhat limited [75]. Commercial enzymatic preparations, rich in glycosidases, are available from Aspergillus niger and can be used in winemaking [76].
Commercial enzyme preparations usually consist of blends of different activities—glucosidases, glucanases, pectinases, and proteases [77]—and the quest for enzymes with more specific characteristics will continue. One major goal of the current research is to study the high endogenous enzyme potential of wine microorganisms.
Under the pH values and sulphur dioxide concentrations typically found in the winemaking process, grape enzymes are often poorly active [78]. Therefore, commercial enzymatic preparations are applied at different stages of the winemaking process for several purposes (lowering viscosity and increasing juice yield, enhancing colour extraction, releasing varietal aromas from precursor compounds, improving the clarification and filterability, and reducing ethyl carbamate formation, among others) as they present a better tolerance and, consequently, activity in the winemaking condition [68,79,80]. The commercial enzymatic preparations from a fungal origin [produced especially by Aspergillus spp. are accepted as GRAS (Generally Recognised as Safe), except glucanases that are produced by direct fermentation—for example, of Trichoderma harzianum, Trichoderma longibrachiatum (T. reesei) and Penicillium funiculosum, Lactobacillus fermentum for urease (EC 3.5.1.5) and hen egg white for Lysozyme], are pectinases, hemicellulases (EC 3.2.1.7 8), β-glucanases (EC 3.2.1.5 8), xylanases, and glycosidases (EC 3.2.1.2 0) that are included in the International Code for Oenological Practices of the International Organisation of Vine and Wine [81]. In addition, Arabinanases (EC 3.2.1.9 9), Cellulases (EC 3.2.1.4), Glucosidases (EC 3.2.1.2 1), Galactanases (EC 3.2.1.8 9), Pectinlyases (EC 4.2.2.1 0), Pectinmethylesterases (EC 3.1.1.1 1) and Polygalacturonases (EC 3.2.1.1 5) are included in International Code for Oenological Practices of the International Organisation of Vine and Wine [81].
4.1. Enzymes from Grape Berry
Grape berry contains two of the three main pectolytic enzymes used in oenology: a pectin-methylesterase (EC 3.1.1.11) mainly localised in the berry skin [82], whose activity is dependent on the grape variety and increased with grape maturity [83], and an endo-polygalacturonase (EC 3.2.1.15) [82]. Both activities decrease at the end of the grape maturity and with the winemaking conditions, such as alcohol content and pH [78]. These grape pectinases are named based on their mode of action on the pectin molecule. These enzymes de-esterify (pectinesterase) or depolymerise (polygalacturonases, polymethylgalacturonases, pectin, and pectate lyases) specific pectic substrates [84].
The most important glycosidase activity is β-D-glucopyranosidase (EC 3.2.1.21); however, α-L-arabinofuranosidases (EC 3.2.1.55) and α-L-rhamnospyranosidase (EC 3.2.1.40) are also found in grape berries, and their activities increase during maturation [85,86]. Nevertheless, grape β-D-glucosidase is weakly active towards grape terphenyl-glycosides during winemaking process conditions at low pH, high levels of sugars (glucose and fructose), polyphenols, and ethanol [85,87,88].
Grapes also contain polyphenol oxidase (EC 1.14.18.1) activity and peroxidase (EC 1.11.1.7) activity that initiates enzymatic browning when grapes are crushed or pressed during the wine production process [89]. Polyphenol oxidase is cupric oxidoreductase, catalysing the hydroxylation of monophenols to ortho-diphenols (cresolase activity) and the oxidation of ortho-diphenols to their corresponding ortho-quinones (catecholase activity) [90]. Subsequent polymerisation of ortho-quinones leads to the formation of brown-red-black pigments [91]. Polyphenol oxidase is named based on the specific substrate specificity such as phenolase, laccase, cresolase, catecholase, tyrosinase, diphenolase, or monophenolase. Grapes contain tyrosinases, catecholase, or catechol oxidase; however, infected grapes with Botrytis cinerea contain laccase, which has no monohydroxylase activity and oxidises a broad spectrum of different substrates [92]. Peroxidase is another oxidoreductase enzyme involved in enzymatic browning, as diphenols may function as reducing substrates in this reaction, and the involvement of this enzyme in browning has been reported by many researchers [93].
4.2. Commercial Enzymatic Preparations Used in Wines Production
The use of commercial enzymatic preparations is justified because the enzymes naturally present in the grapes are neither in enough concentration and not active enough under the winemaking conditions to achieve the expected results. These enzymes naturally present in grapes are not tolerated at low temperatures, grape must pH (2.8–3.8), and are inhibited in particular by the high levels of glucose, sulphur dioxide, phenolic compounds, and alcohol [69]. Therefore, commercial enzyme preparations (pectinases, glucanases, hemicellulases, glycosidases, xylanases, ureases, and lysozyme) are added during the wine production process.
4.2.1. Pectinases
Pectinases or pectinolytic enzymes are groups of enzymes that catalyse the breakdown of pectin (high molecular weight acidic heteropolysaccharide primarily made up of α (1−4) linked d-galacturonic acid residues). They are classified according to their mechanism of action and are used to facilitate different processing steps such as juice extraction and clarification [94,95]. Commercial pectinase enzymatic preparations used in winemaking contain pectolytic enzyme activities such as polygalacturonases, pectin esterases, pectinlyases, and rhamnogalacturonan [85]. Polygalacturonases are the most commonly found pectic enzymes, and they catalyse the hydrolysis of the glycosidic bonds randomly in all chain links (endopolygalacturonase E.C. 3.2.1.15) or from the nonreducing end of homogalacturonan, releasing galacturonic or digalactorunic acid residues (exopolyglacturonases E.C. 3.2.1.67) [96]. Lyases are sub-classified into pectate lyases (E.C. 4.2.2.9 and EC. 4.2.2.2) or pectin lyases (E.C. 4.2.2.10) based on their preference for highly esterified pectinic acid or pectate and the degree of randomness in the eliminative depolymerisation and actions to oligomeric substrates. Pectin lyase is specific for very esterified pectin, but pectates are good substrates for endopectacte lyase which is specific for the penultimate bond at the reducing end of the galacturonan chain, releasing unsaturated digalactosiduronate as the only end-product [79]. Pectin methylesterases (E.C. 3.1.1.11) remove methoxy groups of polygalacturonic acids, releasing methanol and converting pectin into pectate [85].
4.2.2. Cellulases and Hemicellulases
These enzymes are involved in catalysing the degradation of cellulose-type polysaccharides in grape cell walls, mainly through the action of endo-(1-4)-D-glucanases. Various enzymatic activities are required to hydrolyse the cellulose, including endoglucanases (EC 3.2.1.4), exoglucanases (cellobiohydrolases, EC 3.2.1.91), exo-glucohydrolases (EC 3.2.1.74), and β-glucosidases (EC 3.2.1.21) [97]. Endo-glucanases catalyse the hydrolysis of osidic bonds within cellulose in a randomly manner. They also participate in the degradation of xyloglucans, which belong to the group of hemicelluloses. Exo-glucanases release cellobiose and glucose, respectively. They act as relays for the fragments obtained from the action of endo-glucanases. β-glucosidase breaks down cellobiose into glucose [98]. This enzyme also participates in the release of aroma precursors. There are also two main families of xylanases responsible for the hydrolysis of β-1,4 bonds, which are the main component of hemicellulose: endo-β-1,4-xylanase, EC 3.2.1.8, which produced xylose and xylobiose by acting randomly within the chains, and exo-xylanases, which mainly produce D-xylose from the non-reducing ends of the xylans [99].
4.2.3. Glycosidases and Glucosidases
Enzymatic preparations comprise activities that catalyse the hydrolysis of the saccharide portion of glycosylated aromatic compounds in grapes’. These enzymes are specific for sugars (such as glucosidase and galactosidase) and a type of glycosidic bond (e.g., β-glucosidase). They can hydrolyse glycosylated aroma precursors (not odour-active), allowing the compound to become volatile. Monoterpenes (e.g., linalool, citronellol, nerol, geraniol) and C13-norisoprenoid derivatives (β-ionone, β-damascenone), which are responsible for floral and fruity aromas (rose, violet, citrus), are examples of grape varietal volatile compounds that occur in glycosylated precursor forms. When these aroma molecules are linked to sugar molecules (called glycosylated aroma precursors), they are not odour-active. Once the sugar molecules are removed from these glycosylated aroma precursors, they become odour-active [100]. The enzymes involved in this process include α-L-arabinofuranosidase, which catalyses the hydrolysis of the interosidic bond of the precursor arabinofuranosyl glucosides of volatile compounds, α-L-rhamnosidase which allows the sequential hydrolysis of the rhamnosyl glucoside precursors of volatile compounds, and β-D-glucosidase which releases glucose from the volatile compounds. ß-D-glucosidase is the main glycosidase enzyme [87].
4.2.4. Glucanases
Glucanases (EC 3.2.1) are classified as endo- and exo-β-1,3 glucanases and are capable of hydrolysing the glucans produced by Botrytis cinerea, which are extracted into the grape juice and subsequent wine in grapes affected by grey or noble rot [101,102]. β-glucans are high molecular weight (800 kDa) polysaccharides of β-1→3-linked glucose units with β-1→6-linked side chains [101]. The presence of glucans in wine increases viscosity and often makes clarification and filtration processes difficult. Exo-β-1,3-glucanases fragment β-glucan chains by successively cleaving glucose residues from the non-reducing end and releasing glucose as the only hydrolysis product, while endo-β-1,3-glucanases catalyse the intermolecular hydrolysis of β-glucan with the release of oligosaccharides [103]. Thus, these enzymes hydrolysed the β-O-glycosidic linkages of β-glucan chains, leading to the release of glucose and oligosaccharides [104,105].
4.2.5. Urease
Urea originating from yeast activity in wine is the major precursor of ethyl carbamate, which has a potent carcinogenic activity demonstrated by the Food and Drug Administration [106]. Therefore, the maximum content allowed in wines is regulated in some importing countries, such as Canada at 30 μg/L. To limit the presence of ethyl carbamate, the enzymatic degradation of urea appears to be a solution. Urease (urea amidohydrolase EC 3.5.1.5) produced by the strain Lactobacillus fermentum cleaves the ethyl carbamate into carbon dioxide and ammonia [107,108].
4.2.6. Lysozyme
Lysozyme is an enzyme found in hen white eggs and is a peptidoglycan N-acetylmuramide glycanhydrolase (EC 3.2.1.17). Its mechanism of action is related to the hydrolyse of the β-1,4-bonds between N-acetylmuramic acid and N-acetyl-D-glucosamine [109,110]. In this way, the bacterial peptidoglycan cell wall is destabilized, leading to cell lysis. The main use of lysozyme in winemaking is to prevent or delay MLF by inhibiting the growth of lactic acid bacteria, particularly from genera Lactobacillus and Pediococcus, and to diminish the quantities of sulphur dioxide added to the grape must or to the wine [111,112].
4.3. Technological Application of Enzymes at Different Stages of the Winemaking Process
The wine sensory quality attributes, including colour, especially of red wines, are closely related to the volatile and phenolic compounds, as well as aroma precursors, located in the cell walls of the grape skin cells [112]. Therefore, the technological application of enzymes is performed in the different wine production steps: pre-fermentation–juice extraction (pectolytic enzymes, cellulases, hemicellulases), sugar reduction (glucose oxidases), colour extraction (cellulases, hemicellulases, pectolytic enzymes), aroma extraction (glycosidases), polyphenol reduction (phenol oxidases), fermentation, post-fermentation–clarification (proteases), filtration (β-glucanases, cellulases, pectolytic enzymes), microbial stabilisation (lysozyme), and ageing–mouthfeel extraction (β-glucanases, cellulases) [113]. These enzymes are added to improve grape juice yields and colour extraction, to increase varietal aroma compounds expression, to selectively control/inhibit gram-positive bacteria (such as lactic acid bacteria), and improve clarification, stability, and filterability. The main subtract of these oenological enzymes are grape juice or wine macromolecular colloids, specifically targeting polysaccharides. These polysaccharides can either be derived from the grape berry (such as pectin) or synthesised by microorganisms (such as glucan) and introduced into the wine during the winemaking production process.
Pectolytic enzymes are used to degrade the cell wall polysaccharides in grape-berry’s (pectins that are linear polysaccharides of galacturonic acid linked via α-1,4-glycosidic bonds) and, consequently. facilitate the release of juice, aromatic precursors, and phenolic compounds [114]. The application of these enzymes results in the release of a higher quantity of juice (an increase in the extraction rate by 5 to 10%). Additionally, this enzymatic action facilitates the extraction of aromatic precursors from the skins to the juice. The effect varies depending on grape varieties, level of maturity, and time of enzymatic action [115,116]. After extraction, the grape must is naturally cloudy, and may contain residues in varying quantities depending on the intensity of the mechanical treatments applied. Therefore, clarification is necessary to improve the wine’s aromatic quality. Settling and grape must clarification usually occur spontaneously, but for certain grape varieties, pectinases need to be added. The effectiveness of the enzyme at this stage depends on the grape variety, the grape maturity, and the conditions of harvesting and pressing [116]. Studies have shown that adding pectolytic enzymes improves must clarification and positively impacts related parameters such as viscosity and filterability. This is because these enzymes break down complex carbohydrate structures into more soluble oligomers, especially in grape varieties with high pectin levels [117].
Wine colour is one of the most important sensory attributes in red wine evaluation as it significantly influences its commercial acceptance. Anthocyanins and their interactions with other phenolic compounds are responsible for the red wine colour and their stability throughout the ageing process. In grape skins, phenols can be classified into cell-wall phenols, which are bound to polysaccharides by hydrophobic interactions and hydrogen bonds, and non-cell-wall phenols, including phenols restricted in the vacuoles of cells and phenols associated with the cell nucleus [112,118]. Anthocyanins are accumulated in the grape skin, and their extraction occurs during the maceration process. In the traditional winemaking process, only around 40% of the total anthocyanins are extracted from the skins during classic maceration [119,120]. The grape skin cell wall forms a barrier for the diffusion of phenolic and aroma compounds from grapes into the grape must-wine. It is composed of approximately 30% neutral polysaccharides (cellulose, xyloglucan, arabinan, galactan, xylan, and mannan), 20% acidic pectin substances (of which 62% are methyl esterified), about 15% insoluble proanthocyanidins, and less than 5% structural proteins [99,112,121]. Thus, the degradation of cell-wall polysaccharides is an essential step to increase the release of phenols from grape skin [112]. Pectinases, cellulases, and hemicellulolases are enzymes that can catalyse the hydrolysis of bonds in cell-wall polysaccharides. Therefore, the addition of pectolytic enzymes (such as polygalacturonase, pectin methyl esterase, and pectin lyase), cellulolytic enzymes, and hemicellulolytic enzymes during the maceration process of red grapes favour the extraction of anthocyanins from the berry skin, resulting in increased colour intensity of the red wine [4,120,122,123]. Advantages of enzymatic treatment have been described, including higher polyphenol content, increased colour intensity, and more stable colour. Colour-stabilising co-pigmentation reactions of anthocyanins, tannins, and catechins are promoted by enzyme treatment. The main application purpose of these commercial enzymatic preparations is the effective disintegration of the grape cell wall, which constitutes the major diffusion barrier for aroma precursors, pigments, tannins, and other constituents. Nevertheless, the degree of hydrolysis is widely influenced by the grape variety and the type, concentration, and purity of the enzyme(s) applied [124,125].
Volatile compounds coming from the grape are monoterpenes, C13-norisoprenoids, and benzene derivatives, most of which have floral and fruity aromas. However, these compounds could be present either in a free volatile odour form or bound to sugars and rendered odourless non-volatile glycoconjugates [126,127]. These glycosidic aroma precursors can give rise to odorous volatiles using glycosidases enzymes, which are hydrolysed by the action of β-glucosidase activity [126,128,129,130]. The application of β-glucosidase can enhance the aromatic profiles of some wines by hydrolysing the β-1,4 bond, releasing the free volatile component from its conjugate [131]. Due to the limited glycosidase activities related to grape, yeast, and bacteria enzymes, exogenous commercial enzymatic preparations with β-glycosidase activities are used in the wine production process to improve the release of glycosidically bound volatile compounds. These compounds released from glycosidic precursors are of utmost importance to determine wine aroma and varietal character; which are widely recognised as key aspect of wine quality [132].
Another issue is the white wine protein instability that is related to grape proteins, including proteins with defensive and pathogenesis-related (PRP) functions for the grape berry. These proteins are chitinases (28–32 kDa) and thaumatin-like proteins (20–25 kDa) [133,134,135,136,137,138,139]. For many years, the possible use of exogenous proteolytic enzymes for unstable protein degradation and, consequently, stabilising the wine has been evaluated [140]. Nevertheless, these pathogenesis-related proteins are resistant to enzymatic action under winemaking conditions [140,141,142]. Numerous researchers have investigated the effects of microbial proteases [143] such as those from Aspergillus niger [144], Botrytis cinerea [145], and Saccharomyces cerevisiae [146] in decreasing wine haze potential. However, these efforts were not all effective due to the high resistance of wine proteins to proteolysis. Marangon et al. [147] use an acid protease derived from Aspergillus niger, which was rich in aspergillopepsin I and aspergillopepsin II, in combination with flash pasteurisation (75 °C) to remove unstable proteins. The heat treatment was necessary for protein degradation, making them vulnerable to protease. Even though it is a good technological solution, heat treatment limits the applicability of proteases as it requires special equipment and is frequently avoided due to the risk of negative sensory effects. Van Sluyter et al. [148] studied a protease from B. cinerea, BcAP8, that was effective against chitinases during grape juice fermentation without the need for heating. Comuzzo et al. [149] showed that the combined use of heating and proteases in Greek varieties appears to be a promising technique for wine protein stabilisation.
It is also to be considered that the effectiveness of commercial enzyme preparations depends on the purity of their enzymatic activities. Using poorly characterised products can lead to limitations and invalid conclusions when comparing them to other treatments. Due to the nature of commercial enzyme preparations, verify the specific main activity and side activities is not always possible, which makes it difficult to compare commercial products and assess their efficiency and potential detrimental effects [113].
5. Future Trends in Enzyme Production and Usage
Due to great concern for the environment friendly and sustainable production is gaining attention in enzyme bioprocessing industries. Sustainable technologies also have to be competitive in terms of efficiency and cost. Thus, more and more, the use of microbial enzymes in various processes is a trend for value addition, conservation, and quality improvement in the wine and beverage industry [150]. However, natural enzymes, from the raw material or microbial origin, as biocatalysts have performing limits. For example, enzyme denaturation may occur due to low pH and other inabilities such as the pressure of large-scale industrial fermenters and lower catalytic efficiency at ambient conditions [151]. Therefore, the enzymes isolated from natural sources or in their native forms fail to meet the consumer’s requirement in the market. Thus, native enzymes are often engineered to work under non-physiological reactions, designing novel biochemical pathways, and for the production of novel metabolites [151,152]. Enzyme engineering or enzyme technology provides a sustainable and environment-friendly approach to industrial processes. With ongoing advancements, it will be possible to develop more effective and efficient enzymatic systems, contributing to a cleaner and greener environment. Novel enzyme activity and stability should be designed and developed under challenging processing conditions connected with rapid and efficient enzyme purification strategies [8]. Hence, in the coming years, there is great potential for the development of enzyme systems that are both highly effective and efficient, requiring fewer resources and less energy to achieve optimal performance and maximum product yield. Thanks to advancements in molecular biotechnology, it has become increasingly feasible to manipulate existing enzymes and create new ones, making the development of advanced enzyme systems more attainable than ever before [153]. Enzymes from non-GRAS (Genetically Recognised As Safe) microorganisms may be cloned into genetically recognised safe microorganisms for their high-level production [154]. Additionally, the implementation of enzyme immobilisation technology has allowed scientists to find cost-effective alternatives in enzyme applications due to the possibility of increasing product yield, maximum profitability, and minimum risk to the environment [155,156].
Enzyme optimisation in the wine industry involves exploring a range of biotechnological tools, including the use of immobilised enzymes. This technique is effective for enhancing enzyme performance, which involves attaching enzymes to solid supports in order to improve operational stability, increase activity, and reduce costs [157], representing a promising approach to enzyme optimisation in the wine industry. Considering wine processing, the use of immobilised enzymes is a safer and environmentally friendly approach. Immobilised enzymes are easier to remove and do not leave protein residues in the wine; at the same time, they can be re-used repeatedly [113,155]. In addition, immobilised multi-enzymes or co-immobilised cross-linked enzyme aggregates (combi-CLEAs) can be applied when the winemaking process involves the sequential involvement of various enzymes [158].
Another possibility may be to enhance grape and microbial enzyme activities during the different winemaking steps [113].
Another important point that must be considered is that the beverage industry generates a huge quantity of by-products and waste in the form of spent grains and pomace, which are attractive sources of bioactive compounds such as polyphenols, dietary fibre, and essential oils. Through enzymatic bioprocessing, it is possible to efficiently recover these high-value ingredients for further food applications [159], making the reintegration of beverage industrial by-products into the food chain an environment-friendly and sustainable food system.
However, it is important to note that biotechnology and microbial engineering tools may be associated with a negative consumer perception due to limited knowledge about these technologies.
The bioprocessing of extremozymes (enzymes produced by organisms living under extreme conditions) has the potential to expand the application scope of enzymes and further increase their market. Extremozymes are derived from extremophilic microorganisms active and able to grow under extreme conditions [160]. Extremophile microorganisms can be isolated from several extreme environments such as hot springs, hydrothermal vents, saline lakes, and Antarctic/Polar regions [161] and produce enzymes with unique properties that are important for food and beverage applications. Other sources of extremoenzymes (proteases, lipases, β-galactosidase, α-galactosidase, α-amylase, and esterase) include hydrocarbon-contaminated soil, superficial saline soils, acidic creeks and pools, acid mine drainage, brine pools, industrial wastewaters, refineries, exploration sites, mud sediments, and sewage treatment plants [161].
6. Final Remarks
The use of enzymes in the beverage industry has gained increasing attention in recent decades. Enzymes are widely accepted as they provide technological and economic benefits and help solve the insufficient activity of endogenous enzymes. Different enzyme preparations are commercially available, and most of the commercial enzymes used in beverages are mass-produced using fungal hosts (yeasts and filamentous fungi). LAB are also a huge source of enzymes. One limitation that may hinder the industrial production of enzymes extracted from LAB is the slow growth of some strains. As a result, their, direct use in wines to achieve the desired biochemical transformations is commonly employed. Enzymes are used to improve several stages of the process, with pectinases and glycosidases being notable for clarification and aroma release, respectively.
Author Contributions
Conceptualization, F.C., A.I. and A.V.; writing—original draft preparation, F.C., A.I. and A.V.; writing—review and editing, F.C., A.I. and A.V. All authors have read and agreed to the published version of the manuscript.
Funding
This research was funded by the financial support provided to CQ-VR—Chemistry Research Centre—Vila Real (UIDB/00616/2020 and UIDP/00616/2020) by FCT—Portugal and COMPETE.
Institutional Review Board Statement
Not applicable.
Informed Consent Statement
Not applicable.
Data Availability Statement
Not applicable.
Acknowledgments
The authors would like to thank the CQ-VR—Chemistry Research Centre—Vila Real for its financial support.
Conflicts of Interest
The authors declare no conflict of interest.
References
- Robinson, P.K. Enzymes: Principles and biotechnological applications. Essays Biochem. 2015, 59, 1–41. [Google Scholar] [CrossRef] [PubMed]
- Mojsov, K.; Andronikov, D.; Janevski, A.; Jordeva, S.; Zezova, S. Enzymes and wine—the enhanced quality and yield. Adv. Technol. 2015, 4, 94–100. [Google Scholar] [CrossRef]
- Pretorius, I.S. Tailoring wine yeast for the new millennium: Novel approaches to the ancient art of winemaking. Yeast 2000, 16, 675–729. [Google Scholar] [CrossRef] [PubMed]
- Claus, H.; Mojsov, K. Enzymes for Wine Fermentation: Current and Perspective Applications. Fermentation 2018, 4, 52. [Google Scholar] [CrossRef]
- Aredes Fernández, P.A.; Stivala, M.G.; Rodríguez Vaquero, M.J.; Farías, M.E. Increase in antioxidant and antihypertensive activity by Oenococcus oeni in a yeast autolysis wine model. Biotechnol. Lett. 2011, 33, 359–364. [Google Scholar] [CrossRef] [PubMed]
- Hossain, M.B.; Ahmed, L. Chapter 6—Application of Enzymes in Juice Clarification. In Value-Addition in Beverages through Enzyme Technology; Kuddus, M., Hossain, M., Eds.; Academic Press: Cambridge, MA, USA, 2023; pp. 97–104. [Google Scholar] [CrossRef]
- Chandrasekaran, M.; Basheer, S.M.; Chellappan, S.; Krishna, J.G.; Beena, P.S. Enzymes in food and beverage produc-tion: An overview. In Section II: Applications of Enzymes in Food and Beverage Industries; CRC Press: Boca Raton, FL, USA, 2016; pp. 117–139. [Google Scholar]
- Uzuner, S.; Cekmecelioglu, D. Chapter 3—Enzymes in the Beverage Industry. In Enzymes in Food Biotechnology; Kuddus, M., Ed.; Academic Press: Cambridge, MA, USA, 2019; pp. 29–43. ISBN 9780128132807. [Google Scholar] [CrossRef]
- Mazrou, S.; Messaoudi, M.; Begaa, S.; Innocent, C.; Akretche, D. Clarification of the algerian grape juice and their effects on the juice quality. Bull. Chem. Soc. Ethiop. 2020, 34, 1–11. [Google Scholar] [CrossRef]
- Adrio, J.L.; Demain, A.L. Microbial enzymes: Tools for biotechnological processes. Biomol. Ther. 2014, 4, 117–139. [Google Scholar] [CrossRef]
- Markets and Markets. Global Food Enzymes Market Report. Global Food Enzymes Market 2023–2027. 2023, 181p. Available online: https://www.researchandmarkets.com/reports/4894548/global-food-enzymes-market-2023-2027#tag-pos-2 (accessed on 15 February 2023).
- Patel, A.K.; Singhania, R.R.; Pandey, A. Novel enzymatic processes applied to the food industry. Curr. Opin. Food Sci. 2016, 7, 64–72. [Google Scholar] [CrossRef]
- Arnau, J.; Yaver, D.; Hjort, C.M. Strategies and Challenges for the Development of Industrial Enzymes Using Fungal Cell Factories. In Grand Challenges in Fungal Biotechnology; Nevalainen, H., Ed.; Springer International Publishing: Cham, Switzerland, 2020; pp. 179–210. [Google Scholar] [CrossRef]
- Cairns, T.C.; Nai, C.; Meyer, V. How a fungus shapes biotechnology: 100 years of Aspergillus niger research. Fungal. Biol. Biotechnol. 2018, 5, 13. [Google Scholar] [CrossRef]
- Coutinho, P.M.; Reilly, P.J. Glucoamylase structural, functional and evolutionary relationships. Proteins 1997, 29, 334–347. [Google Scholar] [CrossRef]
- Raveendran, S.; Parameswaran, B.; Ummalyma, S.B.; Abraham, A.; Mathew, A.K.; Madhavan, A.; Rebello, S.; Pandey, A. Applications of Microbial Enzymes in Food Industry. Food Technol. Biotechnol. 2018, 56, 16–30. [Google Scholar] [CrossRef] [PubMed]
- Deng, L.; Wang, Z.; Yang, S.; Song, J.; Que, F.; Zhang, H.; Feng, F. Improvement of functional properties of wheat gluten using acid protease from Aspergillus usamii. PLoS ONE 2016, 11, e0160101. [Google Scholar] [CrossRef] [PubMed]
- Copetti, M.A. Fungi as industrial producers of food ingredients. Curr. Opin. Food Sci. 2019, 25, 52–56. [Google Scholar] [CrossRef]
- De Carvalho, C.; da Fonseca, M.M.R. Bacterial whole cell biotransformations: In vivo reactions under in vitro conditions. Dyn. Biochem. Process. Biotechnol. Mol. Biol. 2007, 1, 32–39. [Google Scholar]
- Virdis, C.; Sumby, K.; Bartowsky, E.; Jiranek, V. Lactic acid bacteria in wine: Technological advances and evaluation of their functional role. Front. Microbiol. 2021, 11, 612118. [Google Scholar] [CrossRef]
- Inês, A.; Falco, V. Lactic acid bacteria contribution to wine quality and safety. In Generation of Aromas and Flavours; Vilela, A., Ed.; IntechOpen: London, UK, 2018. [Google Scholar] [CrossRef]
- Paramithiotis, S.; Stasinou, V.; Tzamourani, A.; Kotseridis, Y.; Dimopoulou, M. Malolactic Fermentation—Theoretical Advances and Practical Considerations. Fermentation 2022, 8, 521. [Google Scholar] [CrossRef]
- Liu, S. A review: Malolactic fermentation in wine—Beyond deacidification. J. Appl. Microbiol. 2002, 92, 589–601. [Google Scholar] [CrossRef]
- Arnink, K.; Henick-Kling, T. Influence of Saccharomyces cerevisiae and Oenococcus oeni strains on successful malolactic conversion in wine. Am. J. Enol. Vitic. 2005, 56, 228–237. [Google Scholar] [CrossRef]
- Bartowsky, E.; Burvill, T.; Henschke, P. Diacetyl in Wine: Role of Malolactic Bacteria and Citrate. Aust. N. Z. Grapegrow. Winemak. 1997, 130–135. [Google Scholar]
- Bartowsky, E.; Henschke, P. Management of Malolactic Fermentation for the ‘Buttery’ Diacetyl Flavour in Wine. Aust. N. Z. Grapegrow. Winemak. 2000, 58–67. [Google Scholar]
- Bartowsky, E.; Henschke, P. The ‘buttery’ attribute of wine–diacetyl-desirability, spoilage and beyond. Int. J. Food Microbiol. 2004, 96, 235–252. [Google Scholar] [CrossRef] [PubMed]
- Sumby, K.M.; Jiranek, V.; Grbin, P.R. Ester synthesis and hydrolysis in an aqueous environment, and strain specific changes during malolactic fermentation in wine with Oenococcus oeni. Food Chem. 2013, 141, 1673–1680. [Google Scholar] [CrossRef] [PubMed]
- Günata, Z.; Bitteur, S.; Brillouet, J.-M.; Bayonove, C.; Cordonnier, R. Sequential enzymic hydrolysis of potentially aromatic glycosides from grape. Carbohydrate Res. 1988, 184, 139–149. [Google Scholar] [CrossRef]
- Grimaldi, A.; Bartowsky, E.; Jiranek, V. Screening of Lactobacillus spp. and Pediococcus spp. for glycosidase activities that are important in oenology. J. Appl. Microbiol. 2005, 99, 1061–1069. [Google Scholar] [CrossRef]
- Grimaldi, A.; McLean, H.; Jiranek, V. Identification and partial characterization of glycosidic activities of commercial strains of the lactic acid bacterium, Oenococcus oeni. Am. J. Enol. Vitic. 2000, 51, 362–369. [Google Scholar] [CrossRef]
- Grimaldi, A.; Bartowsky, E.; Jiranek, V. A survey of glycosidase activities of commercial wine strains of Oenococcus oeni. Int. J. Food Microbiol. 2005, 105, 233–244. [Google Scholar] [CrossRef]
- Spano, G.; Rinaldi, A.; Ugliano, M.; Moio, L.; Beneduce, L.; Massa, S. A β-glucosidase gene isolated from wine Lactobacillus plantarum is regulated by abiotic stresses. J. Appl. Microbiol. 2005, 98, 855–861. [Google Scholar] [CrossRef]
- Hernandez-Orte, P.; Cersosimo, M.; Loscos, N.; Cacho, J.; Garcia-Moruno, E.; Ferreira, V. Aroma development from non-floral grape precursors by wine lactic acid bacteria. Food Res. Int. 2009, 42, 773–781. [Google Scholar] [CrossRef]
- Zheng, J.; Wittouck, S.; Salvetti, E.; Franz, C.M.A.P.; Harris, H.M.B.; Mattarelli, P.; O’Toole, P.W.; Pot, B.; Vandamme, P.; Walter, J.; et al. A taxonomic note on the genus Lactobacillus: Description of 23 novel genera, emended description of the genus Lactobacillus Beijerinck 1901, and union of Lactobacillaceae and Leuconostocaceae. Int. J. Syst. Evol. Microbiol. 2020, 4, 2782–2858. [Google Scholar] [CrossRef] [PubMed]
- Lerm, E.; Engelbrecht, L.; du Toit, M. Selection and Characterisation of Oenococcus oeni and Lactobacillus plantarum South African Wine Isolates for Use as Malolactic Fermentation Starter Cultures. S. Afr. J. Enol. Vitic. 2011, 32, 280–295. [Google Scholar] [CrossRef]
- Iorizzo, M.; Testa, B.; Lombardi, S.J.; García-Ruiz, A.; Muñoz-González, C.; Bartolomé, B.; Moreno-Arribas, M.V. Selection and technological potential of Lactobacillus plantarum bacteria suitable for wine malolactic fermentation and grape aroma release. LWT- Food Sci. Technol. 2016, 73, 557–566. [Google Scholar] [CrossRef]
- Krieger-Weber, S.; Heras, J.M.; Suarez, C. Lactobacillus plantarum, a New Biological Tool to Control Malolactic Fermentation: A Review and an Outlook. Beverages 2020, 6, 23. [Google Scholar] [CrossRef]
- Kennison, K.R.; Wilkinson, K.L.; Williams, H.G.; Smith, J.H.; Gibberd, M.R. Smoke-derived taint in wine: Effect of postharvest smoke exposure of grapes on the chemical composition and sensory characteristics of wine. J. Agric. Food Chem. 2007, 55, 10897–10901. [Google Scholar] [CrossRef] [PubMed]
- Jiranek, V. Smoke taint compounds in wine: Nature, origin, measurement and amelioration of affected wines: Smoke taint compounds in wine. Aust. J. Grape Wine Res. 2011, 17, S2–S4. [Google Scholar] [CrossRef]
- Waterhouse, A.L.; Sacks, G.L.; Jeffery, D.W. Understanding Wine Chemistry; John Wiley & Sons, Incorporated: New York, NY, USA, 2016. [Google Scholar]
- Sumby, K.M.; Grbin, P.R.; Jiranek, V. Microbial modulation of aromatic esters in wine: Current knowledge and future prospects. Food Chem. 2010, 121, 1–16. [Google Scholar] [CrossRef]
- Ugliano, M.; Moio, L. Changes in the concentration of yeast-derived volatile compounds of red wine during malolactic fermentation with four commercial starter cultures of Oenococcus oeni. J. Agric. Food Chem. 2005, 53, 10134–10139. [Google Scholar] [CrossRef]
- Antalick, G.; Perello, M.-C.; de Revel, G. Characterization of fruity aroma modifications in red wines during malolactic fermentation. J. Agric. Food Chem. 2012, 60, 12371–12383. [Google Scholar] [CrossRef]
- Costello, P.; Déléris-Bou, M.; Descenzo, R.; Hall, N.; Krieger, S.; Lonvaud Funel, A. Strain selection techniques. In Malolactic Fermentation—Importance of Wine Lactic Acid Bacteria in Winemaking; Morenzoni, R., Specht, K.S., Eds.; Lallemand Inc.: Montréal, QC, Canada, 2015. [Google Scholar]
- Lytra, G.; Miot-Sertier, C.; Moine, V.; Coulon, J.; Barbe, J.-C. Influence of must yeast-assimilable nitrogen content on fruity aroma variation during malolactic fermentation in red wine. Food Res. Int. 2020, 135, 109294. [Google Scholar] [CrossRef]
- Pérez-Martín, F.; Seseña, S.; Izquierdo, P.M.; Palop, M.L. Esterase activity of lactic acid bacteria isolated from malolactic fermentation of red wines. Int. J. Food Microbiol. 2013, 163, 153–158. [Google Scholar] [CrossRef]
- Gammacurta, M.; Lytra, G.; Marchal, A.; Marchand, S.; Christophe Barbe, J.; Moine, V. Influence of lactic acid bacteria strains on ester concentrations in red wines: Specific impact on branched hydroxylated compounds. Food Chem. 2018, 239, 252–259. [Google Scholar] [CrossRef]
- Lasik-Kurdyś, M.; Majcher, M.; Nowak, J. Effects of Different Techniques of Malolactic Fermentation Induction on Diacetyl Metabolism and Biosynthesis of Selected Aromatic Esters in Cool-Climate Grape Wines. Molecules 2018, 23, 2549. [Google Scholar] [CrossRef] [PubMed]
- Claus, H. Microbial Enzymes: Relevance for Winemaking. In Biology of Microorganisms on Grapes, in Must and in Wine, 2nd ed.; König, H., Unden, G., Fröhlich, J., Eds.; Springer International Publishing: Cham, Switzerland, 2017; pp. 315–338. [Google Scholar]
- Matthews, A.; Grbin, P.R.; Jiranek, V. A survey of lactic acid bacteria for enzymes of interest in oenology. Aust. J. Grape Wine Res. 2006, 12, 235–244. [Google Scholar] [CrossRef]
- Nkemnaso, Obi Clifford, Enzymatic Potentials of Lactic Acid Bacteria Isolated from Palm Wine international. J. Bioinform. Biomed. Eng. 2018, 4, 56–61. Available online: http://www.aiscience.org/journal/ijbbe (accessed on 20 January 2023).
- Manca de Nadra, M.C.; Farías, M.E.; Moreno-Arribas, V.; Pueyo, E.; Polo, M.C. A proteolytic effect of Oenococcus oeni on the nitrogenous macromolecular fraction of red wine. FEMS Microbiol. Lett. 1999, 174, 41–47. [Google Scholar] [CrossRef]
- Farías, M.E.; Manca de Nadra, M.C. Purification and partial characterization of Oenococcus oeni exoprotease. FEMS Microbiol. Lett. 2000, 185, 263–266. [Google Scholar] [CrossRef]
- Manca de Nadra, M.C.; Farias, M.E.; Pueyo, E.; Polo, M.C. Protease activity of Oenococcus oeni viable cells on red wine nitrogenous macromolecular fraction in presence of SO2 and ethanol. Food Control 2004, 16, 851–854. [Google Scholar] [CrossRef]
- Folio, P.; Ritt, J.F.; Alexandre, H.; Remize, F. Characterization of EprA, a major extracellular protein of Oenococcus oeni with protease activity. Int. J. Food Microbiol. 2008, 127, 26–31. [Google Scholar] [CrossRef]
- Dicks, L.M.T.; Van Vuuren, H.J.J. Identification and physiological characteristics of heterofermentative strains of Lactobacillus from South African red wines. J. Appl. Bacteriol. 1988, 64, 505–514. [Google Scholar] [CrossRef]
- Vaquero, I.; Marcobal, A.; Munoz, R. Tannase activity by lactic acid bacteria isolated from grape must and wine. Int. J. Food Microbiol. 2004, 96, 199–204. [Google Scholar] [CrossRef]
- Mesas, J.M.; Rodríguez, M.C.; Alegre, M.T. Characterization of lactic acid bacteria from musts and wines of three consecutive vintages of Ribeira Sacra. Lett. Appl. Microbiol. 2011, 52, 258–268. [Google Scholar] [CrossRef] [PubMed]
- Bravo-Ferrada, B.M.; Hollmann, A.; Delfederico, L.; Valdés La Hens, D.; Caballero, A.; Semorile, L. Patagonian red wines: Selection of Lactobacillus plantarum isolates as potential starter cultures for malolactic fermentation. World J. Microbiol. Biotechnol. 2013, 9, 1537–1549. [Google Scholar] [CrossRef] [PubMed]
- Bravo-Ferrada, B.M.; Hollmann, A.; Brizuela, N.; La Hens, D.V.; Tymczyszyn, E.; Semorile, L. Growth and consumption of L-malic acid in wine-like medium by acclimated and non-acclimated cultures of Patagonian Oenococcus oeni strains. Folia Microbiol. 2016, 61, 365–373. [Google Scholar] [CrossRef] [PubMed]
- Callejón, S.; Sendra, R.; Ferrer, S.; Pardo, I. Cloning and characterization of a new laccase from Lactobacillus plantarum J16 CECT 8944 catalyzing biogenic amine degradation. Appl. Microbiol. Biotechnol. 2016, 100, 3113–3124. [Google Scholar] [CrossRef]
- Callejón, S.; Sendra, R.; Ferrer, S.; Pardo, I. Identification of a novel enzymatic activity from lactic acid bacteria able to degrade biogenic amines in wine. Appl. Microbiol. Biotechnol. 2014, 98, 185–198. [Google Scholar] [CrossRef]
- Olmeda, I.; Casino, P.; Collins, R.E.; Sendra, R.; Callejón, S.; Huesa, J.; Soares, A.S.; Ferrer, S.; Pardo, I. Structural analysis and biochemical properties of laccase enzymes from two Pediococcus species. Microb. Biotechnol. 2021, 3, 1026–1043. [Google Scholar] [CrossRef]
- Niu, T.; Li, X.; Guo, Y.; Ma, Y. Identification of a Lactic Acid Bacteria to Degrade Biogenic Amines in Chinese Rice Wine and Its Enzymatic Mechanism. Foods 2019, 8, 312. [Google Scholar] [CrossRef] [PubMed]
- Muhialdin, B.J.; Saari, N.; Meor Hussin, A.S. Review on the Biological Detoxification of Mycotoxins Using Lactic Acid Bacteria to Enhance the Sustainability of Foods Supply. Molecules 2020, 25, 2655. [Google Scholar] [CrossRef]
- Abrunhosa, L.; Inês, A.; Rodrigues, A.I.; Guimarães, A.; Pereira, V.L.; Parpot, P.; Mendes-Faia, A.; Venâncio, A. Biodegradation of ochratoxin A by Pediococcus parvulus isolated from Douro wines. Int. J. Food Microbiol. 2014, 188, 45–52. [Google Scholar] [CrossRef]
- Ottone, C.; Romero, O.; Aburto, C.; Illanes, A.; Wilson, L. Biocatalysis in the winemaking industry: Challenges and opportunities for immobilized enzymes. Compr. Rev. Food Sci. Food Saf. 2019, 19, 595–621 . [Google Scholar] [CrossRef]
- Ducasse, M.A.; Williams, P.; Canal-Llauveres, R.M.; Mazerollest, G.; Cheynier, V.; Doco, T. Effect of macerating enzymes on the oligosaccharide profiles of Merlot red wines. J. Agric. Food Chem. 2011, 59, 6558–6567. [Google Scholar] [CrossRef]
- Ray, R.C.; Rosell, C.M. (Eds.) Microbial Enzyme Technology in Food Applications, 1st ed.; CRC Press: Boca Raton, FL, USA, 2017. [Google Scholar] [CrossRef]
- Sahay, S. Wine Enzymes: Potential and Practices. In Enzymes in Food Biotechnology; Kuddus, M., Ed.; Academic Press: Cambridge, MA, USA, 2019; Chapter 6; pp. 73–92. [Google Scholar] [CrossRef]
- Gaspar, L.M.; Machado, A.; Coutinho, R.; Sousa, S.; Santos, R.; Xavier, A.; Figueiredo, M.; Teixeira, M.F.; Centeno, F.; Simões, J. Development of Potential Yeast Protein Extracts for Red Wine Clarification and Stabilization. Front. Microbiol. 2019, 10, 2310. [Google Scholar] [CrossRef] [PubMed]
- Fia, G. Wine Lees: Traditional and Potential Innovative Techniques for their Exploitation in Winemaking. In Grape and Wine Biotechnology; IntechOpen: London, UK, 2016; pp. 345–359. [Google Scholar] [CrossRef]
- De Iseppi, A.; Lomolino, G.; Marangon, M.; Curioni, A. Current and future strategies for wine yeast lees valorization. Food Res. Int. 2020, 137, 109352. [Google Scholar] [CrossRef] [PubMed]
- Maicas, S.; Mateo, J.J. Microbial Glycosidases for Wine Production. Beverages 2016, 2, 20. [Google Scholar] [CrossRef]
- Karnišová-Potocká, E.; Mastihubová, M.; Mastihuba, V. Apiose-Relevant Glycosidases. Catalysts 2021, 11, 1251. [Google Scholar] [CrossRef]
- Hüfner, E.; Haßelbeck, G. Application of microbial enzymes during winemaking. In Biology of Microorganisms on Grapes, in Must and in Wine, 2nd ed.; König, H., Unden, G., Fröhlich, J., Eds.; Springer International Publishing: Cham, Switzerland, 2017; pp. 635–658. [Google Scholar]
- Van Rensburg, P.; Pretorius, I.S. Enzymes in winemaking. Harnessing Natural Catalysts for Efficient Biotransformations—A Review. S. Afr. J. Enol. Vitic. 2000, 21, 52–73. [Google Scholar]
- OIV (Organisation International de la Vigne et du Vin). International Code Oenological Practices; Edition Officielle: Paris, France, 2022. [Google Scholar]
- OIV (Organisation International de la Vigne et du Vin). International Oenological Codex; Edition Officielle: Paris, France, 2022. [Google Scholar]
- Deytieux-Belleau, C.; Vallet, A.; Donéche, B.; Geny, L. Pectin methylesterase and polygalacturonase in the developing grape skin. Plant Physiol. Biochem. 2008, 46, 638e646. [Google Scholar] [CrossRef]
- Villettaz, J.C. Les enzymes en œnologie. Bull. de l’O.I.V. 1984, 635, 19–29. [Google Scholar]
- Pretorius, I.S. Utilisation of polysaccharides by Saccharomyces cerevisiae. In Yeast Sugar Metabolism—Biochemistry, Genetics, Biotechnology and Applications; Zimmermann, F.K., Entaian, K.D., Eds.; Technomic Publishing Co.: Lancaster, PA, USA, 1997; pp. 459–501. [Google Scholar]
- Aryan, A.R.; Wilson, B.; Strauss, C.R.; Williams, P.J. The Properties of Glycosidases of Vitis vinifera and a Comparison of Their Beta-Glycosidase Activity with That of Exogenous Enzymes. An Assessment of Possible Applications in Enology. Am. J. Enol. Vitic. 1987, 38, 182–188. [Google Scholar] [CrossRef]
- Günata, Y.Z.; Biron, C.; Sapis, J.C.; Bayonove, C. Glycosidase activities in sound and rotten grapes in relation to hydrolysis of grape monoterpenyl glycosides. Vitis 1989, 28, 191–197. [Google Scholar]
- Sarry, J.E.; Günata, Z. Plant and Microbial Glycoside Hydrolases: Volatile Release from Glycosidic Aroma Precursors. Food Chem. 2004, 87, 509–521. [Google Scholar] [CrossRef]
- Loscos, N.; Hernandez-Orte, P.; Cacho, J.; Ferreira, V. Release and formation of varietal aroma compounds during alcoholic fermentation from non-floral grape odorless flavor precursors fractions. J. Agric. Food Chem. 2007, 55, 6674–6684. [Google Scholar] [CrossRef] [PubMed]
- López-Miranda, S.; Hernández-Sánchez, P.; Serrano-Martínez, A.; Hellínb, J.; Fenoll, P.; Núñez-Delicado, E. Effect of ripening on protein content and enzymatic activity of Crimson Seedless table grape. Food Chem. 2011, 127, 481–486. [Google Scholar] [CrossRef] [PubMed]
- Orenes-Piñero, E.; García-Carmona, F.; Sánchez-Ferrer, A. Latent of polyphenol oxidase from quince fruit pulp (Cydonia oblonga): Purification, activation and some properties. J. Sci. Food Agric. 2006, 86, 2172–2178. [Google Scholar] [CrossRef]
- Gandía-Herrero, F.; García-Carmona, F.; Escribano, J. Purification and characterization of a latent polyphenol oxidase from beet root (Beta vulgaris L.). J. Agric. Food Chem. 2004, 52, 609–615. [Google Scholar] [CrossRef] [PubMed]
- Fronk, P.; Hartmann, H.; Bauer, M.; Solem, E.; Jaenicke, E.; Tenzer, S.; Decker, H. Polyphenoloxidase from Riesling and Dornfelder wine grapes (Vitis vinfera) is a tyrosinase. Food Chem. 2015, 183, 49–57. [Google Scholar] [CrossRef] [PubMed]
- Richard-Forget, F.C.; Gauillard, F.A. Oxidation of chlorogenic acid, catechins and 4-methylcatechol in model solutions by combinations of pear (Pyrus communis cv. Williams) polyphenol oxidase and peroxidase: A possible involvement of peroxidase in enzymatic browning. J. Agric. Food Chem. 1997, 45, 2472–2476. [Google Scholar] [CrossRef]
- Kavuthodi, B.; Sebastian, D. Review on bacterial production of alkaline pectinase with special emphasis on Bacillus species. Biosci. Biotechnol. Res. Commun. 2018, 11, 18–30. [Google Scholar] [CrossRef]
- Sudeep, K.C.; Upadhyaya, J.; Joshi, D.R.; Lekhak, B.; Chaudhary, D.K.; Pant, B.R.; Bajgai, T.R.; Dhital, R.; Khanal, S.; Koirala, N.; et al. Production, Characterization, and Industrial Application of Pectinase Enzyme Isolated from Fungal Strains. Fermentation 2020, 6, 59. [Google Scholar] [CrossRef]
- Cornuault, V.; Posé, S.; Knox, J.P. Disentangling pectic homogalacturonan and rhamnogalacturonan-I polysaccharides: Evidence for sub-populations in fruit parenchyma systems. Food Chem. 2018, 246, 275–285. [Google Scholar] [CrossRef]
- Kuhad, R.C.; Gupta, R.; Singh, A. Microbial cellulases and their industrial applications. Enzyme Res. 2011, 2011, 280696. [Google Scholar] [CrossRef]
- Gilkes, N.R.; Henrissat, B.; Kilburn, D.G.; Miller, R.C.; Warren, R.A.J. Domains in microbial b-1-4-glycanases: Sequence conservation, function, and enzymes families. Microbiol. Rev. 1991, 55, 303–315. [Google Scholar] [CrossRef] [PubMed]
- Doco, T.; Williams, P.; Pauly, M.; O’Neill, M.A.; Pellerin, P. Polysaccharides from grape berry cell walls. Part II. Structuralcharacterization of the xyloglucan polysaccharides. Carbohydr. Polym. 2003, 53, 253e261. [Google Scholar] [CrossRef]
- Hjelmeland, A.K.; Ebeler, S.E. Glycosidically Bound Volatile Aroma Compounds in Grapes and Wine: A Review. Am. J. Enol. Vitic. 2015, 66, 1–11. [Google Scholar] [CrossRef]
- Dubourdieu, D.; Ribéreau-Gayon, P. Structure of the exocellular beta-D-glucan from Botrytis cinerea. Carbohydr. Res. 1981, 93, 294–299. [Google Scholar] [CrossRef]
- Dubourdieu, D.; Desplanques, C.; Villettaz, J.-C.; Ribéreau-Gayon, P. Investigations of an industrial β-D-glucanase from Trichoderma harzianum. Carbohydr. Res. 1985, 144, 277–287. [Google Scholar] [CrossRef]
- Venturi, F.; Andrich, G.; Quartacci, M.F.; Sanmartin, C.; Andrich, L.; Zinnai, A. A kinetic method to identify the optimum temperature for glucanase activity. S. Afr. J. Enol. Vitic. 2013, 34, 281–286. [Google Scholar] [CrossRef]
- Villettaz, J.-C.; Steiner, D.; Trogus, H. The use of glucanase as an enzyme in wine clarification and filtration. Am. J. Enol. Vitic. 1984, 35, 253–256. [Google Scholar] [CrossRef]
- Nebreda, A.R.; Villa, T.G.; Villanueva, J.R.; del Rey, F. Cloning of genes related to exo-beta-glucanase production in Saccharomyces cerevisiae: Characterization of an exo-beta-glucanase structural gene. Gene 1986, 47, 245–259. [Google Scholar] [CrossRef]
- Gowd, V.; Su, H.; Karlovsky, P.; Chen, W. Ethyl carbamate: An emerging food and environmental toxicant. Food Chem. 2018, 248, 312–321. [Google Scholar] [CrossRef]
- Fujinawa, S.; Burns, G.; De La Teja, P. Application of acid urease to reduction of urea in commercial wines. Am. J. Enol. Vitic. 1990, 41, 350–354. [Google Scholar] [CrossRef]
- Fidaleo, M.; Esti, M.; Moresi, M. Assessment of urea degradation rate in model wine solutions by acid urease from Lactobacillus fermentum. J. Agric. Food. Chem. 2006, 54, 6226–6235. [Google Scholar] [CrossRef] [PubMed]
- Ough, C.S.; Trioli, G. Urea removal from wine by an acid urease. Am. J. Enol. Vitic. 1988, 39, 303. [Google Scholar] [CrossRef]
- Proctor, V.A.; Cunningham, F.E. The chemistry of lysozyme and its use as a food preservative and a pharmaceutical. CRC Crit. Rev. Food Sci. Nutr. 1988, 26, 359–395. [Google Scholar] [CrossRef] [PubMed]
- Gerbaux, V.; Villa, A.; Monamy, C.; Bertand, A. Use of lysozyme to inhibit malolactic fermentation and to stabilize wine after malolactic fermentation. Am. J. Enol. Vitic. 1997, 48, 49–54. [Google Scholar] [CrossRef]
- Liburdi, K.; Benucci, I.; Esti, M. Lysozyme in wine: An overview of current and future applications. Compr. Rev. Food Sci. Food Saf. 2014, 13, 1062–1073. [Google Scholar] [CrossRef]
- Pinelo, M.; Arnous, A.; Meyer, A.S. Upgrading of grape skins: Significance of plant cell wall structural components and extraction techniques for phenol release. Trends Food Sci. Technol. 2006, 17, 579–590. [Google Scholar] [CrossRef]
- Espejo, F. Role of commercial enzymes in wine production: A critical review of recent research. J. Food Sci. Technol. 2021, 58, 9–21. [Google Scholar] [CrossRef]
- Garg, G.; Singh, A.; Kaur, A.; Singh, R.; Kaur, J.; Mahajan, R. Microbial pectinases: An ecofriendly tool of nature for industries. 3 Biotech 2016, 6, 47. [Google Scholar] [CrossRef]
- Guerin, L.; Chatelet, B.; Anneraud, C.; Vinsonneau, E.; Davaud, F.; Solanet, D.; Vuchot, P. Les enzymes en œnologie- 2ème volet: Intérêt dans les opérations fermentaires sur vin rouge. Rev. Française D’œnologie 2011, 244, 7–18. [Google Scholar]
- Ducasse, M.-A.; Canal-Llauberes, R.-M.; de Lumley, M.; Williams, P.; Souquet, J.-M.; Fulcrand, H.; Doco, T.; Cheynier, V. Effect of macerating enzyme treatment on the polyphenol and polysaccharide composition of red wines. Food Chem. 2010, 118, 369–376. [Google Scholar] [CrossRef]
- Samoticha, J.; Wojdylo, A.; Chmielewska, J.; Politowicz, J.; Szumny, A. The effects of enzymatic pre-treatment and type of yeast on chemical properties of white wine. LWT Food Sci. Technol. 2017, 79, 445–453. [Google Scholar] [CrossRef]
- Fontes, N.; Gerós, H.; Delrot, S. Grape berry vacuole: A complex and heterogeneous membrane system specialized in the accumulation of solutes. Am. J. Enol. Vitic. 2011, 62, 270–278. [Google Scholar] [CrossRef]
- El Darra, N.E.; Turk, M.F.; Ducasse, M.A.; Grimi, N.; Maroun, R.G.; Louka, N.; Vorobiev, E. Changes in polyphenol profiles and colour composition of freshly fermented model wine due to pulsed electric field, enzymes and thermovinification pretreatments. Food Chem. 2016, 194, 944–950. [Google Scholar] [CrossRef] [PubMed]
- Romero-Cascales, I.; Ros-García, J.M.; López-Roca, J.M.; Gómez-Plaza, E. The effect of a commercial pectolytic enzyme on grape skin cell wall degradation and colour evolution during the maceration process. Food Chem. 2012, 130, 626–631. [Google Scholar] [CrossRef]
- Lecas, M.; Brillouet, J.-M. Cell wall composition of grape berry skins. Phytochemistry 1994, 35, 1241e1243. [Google Scholar] [CrossRef]
- Bautista-Ortín, A.B.; Martínez-Cutillas, A.; Ros-García, J.; López-Roca, J.M.; Gómez-Plaza, E. Improving colour extraction and stability in red wines: The use of maceration enzymes and enological tannins. Int. J. Food Sci. 2005, 40, 867–878. [Google Scholar] [CrossRef]
- Kelebek, H.; Canbas, A.; Cabaroglu, T.; Selli, S. Improvement of anthocyanin content in the cv. Öküzgözü wines by using pectolytic enzymes. Food Chem. 2007, 105, 334–339. [Google Scholar] [CrossRef]
- Li, S.Y.; Liu, P.T.; Pan, Q.H.; Shi, Y.; Duan, C.Q. Association between modification of phenolic profiling and development of wine color during alcohol fermentation. J. Food Sci. 2015, 80, C703–C710. [Google Scholar] [CrossRef] [PubMed]
- Sacchi, K.L.; Bisson, L.F.; Adams, D.O. A review of the effect of winemaking techniques on phenolic extraction in red wines. Am. J. Enol. Vitic. 2005, 56, 197–206. [Google Scholar] [CrossRef]
- Maicas, S.; Mateo, J.J. Hydrolysis of terpenyl glycosides in grape juice and other fruit juices: A review. Appl. Microbiol. Biotechnol. 2005, 67, 322–335. [Google Scholar] [CrossRef]
- Black, C.A.; Parker, M.; Siebert, T.E.; Capone, D.L.; Francis, I.L. Terpenoids and their role in wine flavour: Recent advances. Aust. J. Grape Wine Res. 2015, 21, 582–600. [Google Scholar] [CrossRef]
- Sánchez-Palomo, E.; Díaz-Maroto Hidalgo, M.C.; González-Viñas, M.A.; Pérez-Coello, M.S. Aroma enhancement in wines from different grape varieties using exogenous glycosidases. Food Chem. 2005, 92, 627–635. [Google Scholar] [CrossRef]
- Pogorzelski, E.; Wilkowska, A. Flavour enhancement through the enzymatic hydrolysis of glycosidic aroma precursors in juices and wine beverages: A review. Flavour. Fragr. J. 2007, 22, 251–254. [Google Scholar] [CrossRef]
- Bisotto, A.; Julien, A.; Rigou, P.; Schneider, R.; Salmon, J.M. Evaluation of the inherent capacity of commercial yeast strains to release glycosidic aroma precursors from Muscat grape must. Aust. J. Grape Wine Res. 2015, 21, 194–199. [Google Scholar] [CrossRef]
- Di Profio, F.; Reynolds, A.G.; Kasimos, A. Canopy management and Eenzyme impacts on Merlot, Cabernet Franc, and Cabernet Sauvignon. I. Yield and berry composition. Am. J. Enol. Vitic. 2011, 62, 139–151. [Google Scholar] [CrossRef]
- González-Barreiro, C.; Rial-Otero, R.; Cancho-Grande, B.; Simal-Gándara, J. Wine aroma compounds in grapes: A critical review. Crit. Rev. Food Sci. Nutr. 2015, 55, 202–218. [Google Scholar] [CrossRef]
- Waters, E.J.; Shirley, N.J.; Williams, P.J. Nuisance proteins of wine are grape pathogenesisrelated proteins. J. Agric. Food Chem. 1996, 44, 3–5. [Google Scholar] [CrossRef]
- Waters, E.J.; Hayasaka, Y.; Tatersall, D.B.; Adams, K.S.; Williams, P.J. Sequence analysis of grape (Vitis vinifera) berry chitinases that cause haze formation in wines. J. Agric. Food Chem. 1998, 45, 4950–4957. [Google Scholar] [CrossRef]
- Marangon, M.; Van Sluyter, S.C.; Neilson, K.A.; Chan, C.; Haynes, P.A.; Waters, E.J.; Falconer, R.J. Roles of grape thaumatin-like protein and chitinase in white wine haze formation. J. Agric. Food Chem. 2011, 59, 733–740. [Google Scholar] [CrossRef]
- Marangon, M.; Van Sluyter, S.C.; Waters, E.J.; Menz, R.I. Structure of haze forming proteins in white wines: Vitis vinifera Thaumatin-like proteins. PLoS ONE 2014, 9, e113757. [Google Scholar] [CrossRef]
- Gazzola, D.; Van Sluyter, S.C.; Curioni, A.; Waters, E.J.; Marangon, M. Roles of proteins, polysaccharides, and phenolics in haze formation in white wine via reconstitution experiments. J. Agric. Food Chem. 2012, 60, 10666–10673. [Google Scholar] [CrossRef] [PubMed]
- Cosme, F.; Fernandes, C.; Ribeiro, T.; Filipe-Ribeiro, L.; Nunes, F.M. White Wine Protein Instability: Mechanism, Quality Control and Technological Alternatives for Wine Stabilisation—An Overview. Beverages 2020, 6, 19. [Google Scholar] [CrossRef]
- Arenas, I.; Ribeiro, M.; Filipe-Ribeiro, L.; Vilamarim, R.; Costa, E.; Siopa, J.; Cosme, F.; Nunes, F.M. Effect of Pre-Fermentative Maceration and Fining Agents on Protein Stability, Macromolecular, and Phenolic Composition of Albariño White Wines: Comparative Efficiency of Chitosan, k-Carrageenan and Bentonite as Heat Stabilisers. Foods 2021, 10, 608. [Google Scholar] [CrossRef] [PubMed]
- Heatherbell, D.; Ngaba, P.; Fombin, J.; Watson, B.; Garcia, Z.; Flores, J.; Hsu, J. Recent developments in the application of ultrafiltration and protease enzymes to grape juice and wine processing. In Proceedings of the International Symposium on Cool Climate Viticulture and Enology, Eugene, OR, USA, 25–28 June 1984; Oregon State University: Corvallis, OR, USA, 1984; pp. 418–445. [Google Scholar]
- Waters, E.J.; Wallace, W.; Williams, P.J. Identification of heat-unstable wine proteins and their resistance to peptidases. J. Agric. Food Chem. 1992, 40, 1514–1519. [Google Scholar] [CrossRef]
- Waters, E.J.; Peng, Z.; Pocock, K.F.; Williams, P.J. Proteins in white wine, II: Their resistance to proteolysis is not due to either phenolic association or glycosylation. Aust. J. Grape Wine Res. 1995, 1, 94–99. [Google Scholar] [CrossRef]
- Theron, L.W.; Divol, B. Microbial aspartic proteases: Current and potential applications in industry. Appl. Microbiol. Biotechnol. 2014, 98, 8853–8868. [Google Scholar] [CrossRef]
- Bakalinsky, A.T.; Boulton, R. The study of an immobilized acid protease for the treatment of wine proteins. Am. J. Enol. Vitic. 1985, 36, 23–29. [Google Scholar] [CrossRef]
- Cilindre, C.; Castro, A.J.; Clément, C.; Jeandet, P.; Marchal, R. Influence of Botrytis cinerea infection on Champagne wine proteins (characterized by two-dimensional electrophoresis/immunodetection) and wine foaming properties. Food Chem. 2007, 103, 139–149. [Google Scholar] [CrossRef]
- Younes, B.; Cilindre, C.; Villaume, S.; Parmentier, M.; Jeandet, P.; Vasserot, Y. Evidence for an extracellular acid proteolytic activity secreted by living cells of Saccharomyces cerevisiae PlR1: Impact on grape proteins. J. Agric. Food Chem. 2011, 59, 6239–6246. [Google Scholar] [CrossRef]
- Marangon, M.; Van Sluyter, S.C.; Robinson, E.M.; Muhlack, R.A.; Holt, H.E.; Haynes, P.A.; Godden, P.W.; Smith, P.A.; Waters, E.J. Degradation of white wine haze proteins by Aspergillopepsin I and II during juice flash pasteurization. Food Chem. 2012, 135, 1157–1165. [Google Scholar] [CrossRef]
- Van Sluyter, S.C.; McRae, J.M.; Falconer, R.J.; Smith, P.A.; Bacic, A.; Waters, E.J.; Marangon, M. Wine protein haze: Mechanisms of formation and advances in prevention. J. Agric. Food. Chem. 2015, 63, 4020–4030. [Google Scholar] [CrossRef] [PubMed]
- Comuzzo, P.; Voce, S.; Fabris, J.; Cavallaro, A.; Zanella, G.; Karpusas, M.; Kallithraka, S. Effect of the combined application of heat treatment and proteases on protein stability and volatile composition of Greek white wines. Oeno One 2020, 54, 175–188. [Google Scholar] [CrossRef]
- Talavera-Caro, A.G.; Alva-Sánchez, D.L.; Sosa-Herrera, A.; Sánchez-Muñoz, M.A.; Hernández-De Lira, I.O.; Hernández-Beltran, J.U.; Hernández-Almanza, A.Y.; Balagurusamy, N. Chapter 11—Emerging trends and future perspectives on enzyme prospection with reference to food processing. In Value-Addition in Food Products and Processing through Enzyme Technology; Kuddus, M., Aguilar, C.N., Eds.; Academic Press: Cambridge, MA, USA, 2022; pp. 139–151. [Google Scholar] [CrossRef]
- Sharma, A.; Gupta, G.; Ahmad, T.; Mansoor, S.; Kaur, B. Enzyme Engineering: Current Trends and Future Perspectives. Food Rev. Int. 2021, 37, 121–154. [Google Scholar] [CrossRef]
- Singh, R.; Kumar, M.; Mittal, A.; Mehta, P.K. Microbial Enzymes: Industrial Progress in 21st Century. 3 Biotech 2016, 6, 174. [Google Scholar] [CrossRef] [PubMed]
- 153Yang, H.; Li, J.; Shin, H.D.; Du, G.; Liu, L.; Chen, J. Molecular engineering of industrial enzymes: Recent advances and future prospects. Appl. Microbiol. Biotechnol. 2014, 98, 23–29. [Google Scholar]
- Solano, F. Enzyme Engineering: Old and New Approaches. Enzyme Eng. 2015, 4, 1. [Google Scholar] [CrossRef]
- Cosme, F.; Vilela, A. Chitin and Chitosan in the Alcoholic and Non-Alcoholic Beverage Industry: An Overview. Appl. Sci. 2021, 11, 11427. [Google Scholar] [CrossRef]
- Kaushal, J.; Singh, G.; Arya, S.K. Chapter 36—Emerging trends and future prospective in enzyme technology. In Value-Addition in Food Products and Processing through Enzyme Technology; Kuddus, M., Aguilar, C.N., Eds.; Academic Press: Cambridge, MA, USA, 2022; pp. 491–503. [Google Scholar] [CrossRef]
- Bleve, G.; Tufariello, M.; Vetrano, C.; Mita, G.; Grieco, F. Simultaneous alcoholic and malolactic fermentations by Saccharomyces cerevisiae and Oenococcus oeni cells co-immobilized in alginate beads. Front. Microbiol. 2016, 7, 943. [Google Scholar] [CrossRef]
- Ahumada, K.; Martínez-Gil, A.; Moreno-Simunovic, Y.; Illanes, A.; Wilson, L. Aroma Release in Wine Using Co-Immobilized Enzyme Aggregates. Molecules 2016, 8, 1485. [Google Scholar] [CrossRef]
- Moirangthem, K.; Rai, D.-K.; Coda, R. Chapter 2—Enzyme technology for value addition in the beverage industry waste. In Value-Addition in Beverages through Enzyme Technology; Kuddus, M., Hossain, M., Eds.; Academic Press: Cambridge, MA, USA, 2023; pp. 27–50. ISBN 9780323856836. [Google Scholar] [CrossRef]
- Elleuche, S.; Schröder, C.; Sahm, K.; Antranikian, G. Extremozymes—Biocatalysts with unique properties from extremophilic microorganisms. Curr. Opin. Biotechnol. 2014, 29, 116–123. [Google Scholar] [CrossRef]
- Akanbi, T.O.; Agyei, D.; Saari, N. Chapter 46—Food Enzymes From Extreme Environments: Sources and Bioprocessing. In Enzymes in Food Biotechnology; Kuddus, M., Ed.; Academic Press: Cambridge, MA, USA, 2019; pp. 795–816. [Google Scholar] [CrossRef]
Disclaimer/Publisher’s Note: The statements, opinions and data contained in all publications are solely those of the individual author(s) and contributor(s) and not of MDPI and/or the editor(s). MDPI and/or the editor(s) disclaim responsibility for any injury to people or property resulting from any ideas, methods, instructions or products referred to in the content. |
© 2023 by the authors. Licensee MDPI, Basel, Switzerland. This article is an open access article distributed under the terms and conditions of the Creative Commons Attribution (CC BY) license (https://creativecommons.org/licenses/by/4.0/).